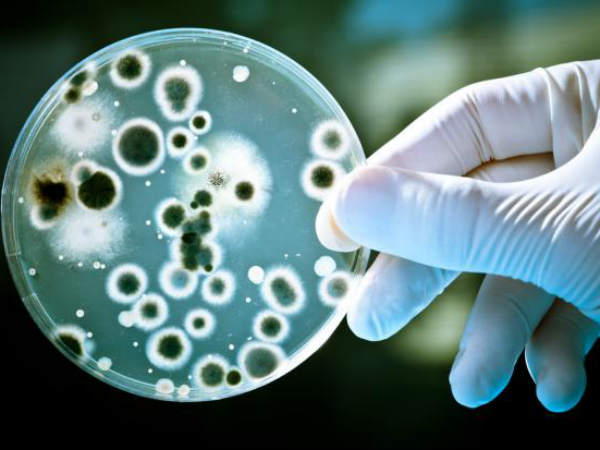

యాంటీబయోటిక్స్తో డేంజర్: హాస్పిటల్స్లో విజృంభిస్తున్న కొత్త రకం బ్యాక్టీరియా
ప్రపంచ వ్యాప్తంగా ఉన్న హాస్పిటల్ వార్డుల్లోకి ఓ కొత్త రకమైన బ్యాక్టీరియా ప్రవేశిస్తున్నట్లు ఆస్ట్రేలియా శాస్త్రవేత్తలు తమ పరిశోధనల ద్వారా వెల్లడించారు. స్టాఫిలోకోకస్ అనే ఈ బ్యాక్టీరియాని తొలగించేందుకు పలు రకాల యాంటీబైటిక్స్ వినియోగించినప్పటికీ పెద్దగా ఉపయోగం లేకుండా పోయిందని వారు తెలిపారు. పైగా ఈ బ్యాక్టీరియా యాంటిబయోటిక్స్ నుంచే వస్తోందని వారు హెచ్చరించారు. ఇది సోకితే ప్రాణాలకు ప్రమాదమని వార్నింగ్ ఇస్తున్నారు. ఈ బ్యాక్టీరియాపై పలు శాంపుల్స్ ఆస్ట్రేలియా హాస్పిటల్స్ నుంచి సేకరించి పరిశోధనలు జరిపినట్లు మెల్బోర్న్ యూనివర్శిటీ శాస్త్రవేత్త బెన్ హోడెన్ తెలిపారు. అయితే ప్రపంచ దేశాల్లో ఈ బ్యాక్టీరియా ఉందని ఆయన వెల్లడించారు.
మనిషి ప్రాణాలు తీసే ఈ బ్యాక్టీరియా పేరు స్టాఫిలోకోకస్ అని శాస్త్రవేత్తలు తెలిపారు. మనిషి చర్మంపై ఇది వస్తుందని ఎక్కువగా పెద్ద వయసున్న వ్యక్తుల్లో ఈ బ్యాక్టీరియా సోకుతుందని వివరించారు. ఇవి ఎక్కువగా అవయవ మార్పిడి జరిగిన పేషంట్లలో కూడా ఈ బ్యాక్టీరియా కనిపిస్తుందని వెల్లడించారు. హస్పిటల్లో చికిత్స పొందుతున్న పేషంట్లలో ఈ బ్యాక్టీరియా ఉన్నట్లు సైంటిస్టులు చెప్పారు. స్టాఫిలోకోకస్ అనే ఈ బ్యాక్టీరియాను తొలగించాలంటే చాలా కష్టమని వారు చెప్పారు.
ప్రపంచ వ్యాప్తంగా ఉన్న 78 హాస్పిటల్స్ నుంచి తీసుకొచ్చిన శాంపిల్స్ను పరిశీలించింది బెన్ హోడెన్ బృందం. బ్యాక్టీరియా కలిగిన కొన్ని మరకలతో డీఎన్ఏలో చిన్న మార్పులను గమనించినట్లు బృందం పేర్కొంది. ఈ బ్యాక్టీరియాను తొలగించేందుకు శక్తివంతమైన యాంటీబైటిక్స్ వినియోగించడం వల్ల ఫలితం ఉండదని తెలిపారు. పైగా ఎక్కవ పవర్ ఉన్న యాంటిబైటిక్స్ వాడితే విషం అయ్యే ప్రమాదం ఉందని వెల్లడించారు. ఒక్క వ్యాధిని నయం చేసేందుకు పలు రకాల మందులు ఒకేసారి వేసుకుంటే వ్యాధి నయమవదని కూడా వారు చెప్పారు.
హాస్పిటల్స్లోని ఇంటెన్సివ్ కేర్ యూనిట్లలో అధిక మొత్తంలో యాంటిబైటిక్స్ వినియోగించడం వల్ల ఈ బ్యాక్టీరియా విస్తృతంగా వ్యాప్తి చెందుతోందన్నారు. దీంతో అప్పటికే ఇంటెన్సివ్ కేర్లో ఉన్న పేషెంట్ల ఆరోగ్య పరిస్థితి మరింత దిగజారిపోతోందని.. దీనికోసం పెద్ద ఎత్తున పవర్ ఫుల్ మందులను డాక్టర్లు ఇస్తున్నారని చెప్పారు. ఇప్పటికే యాంటిబైటిక్స్ ఎక్కువగా ఉపయోగించడం వల్ల ప్రాణాలకు ముప్పు తెచ్చుకుంటున్నామని ఐక్యరాజ్యసమితి ఆరోగ్య సంస్థ హెచ్చరించింది. హాస్పిటల్ వార్డుల్లో ఉన్న ఆల్కహాల్తో తయారు చేయబడ్డ హ్యాండ్ వాష్లు కానీ, శానిటైజర్ల ద్వారా కూడా కొన్ని కొత్త తరహా బ్యాక్టీరియాలు వ్యాప్తి చెందుతున్నట్లు గతనెలలోనే ఓ ఆస్ట్రేలియా పరిశోధన సంస్థ వెల్లడించింది. యాంటీ బయోటిక్స్ను హాస్పిటల్స్లో ఎక్కువగా వాడటం వల్లనే బ్యాక్టీరియా సోకుతోందని అది ప్రాణాలను హరించి వేస్తోందని ఆస్ట్రేలియా పరిశోధకుడు హోడెన్ చెబుతున్నారు.












Click it and Unblock the Notifications